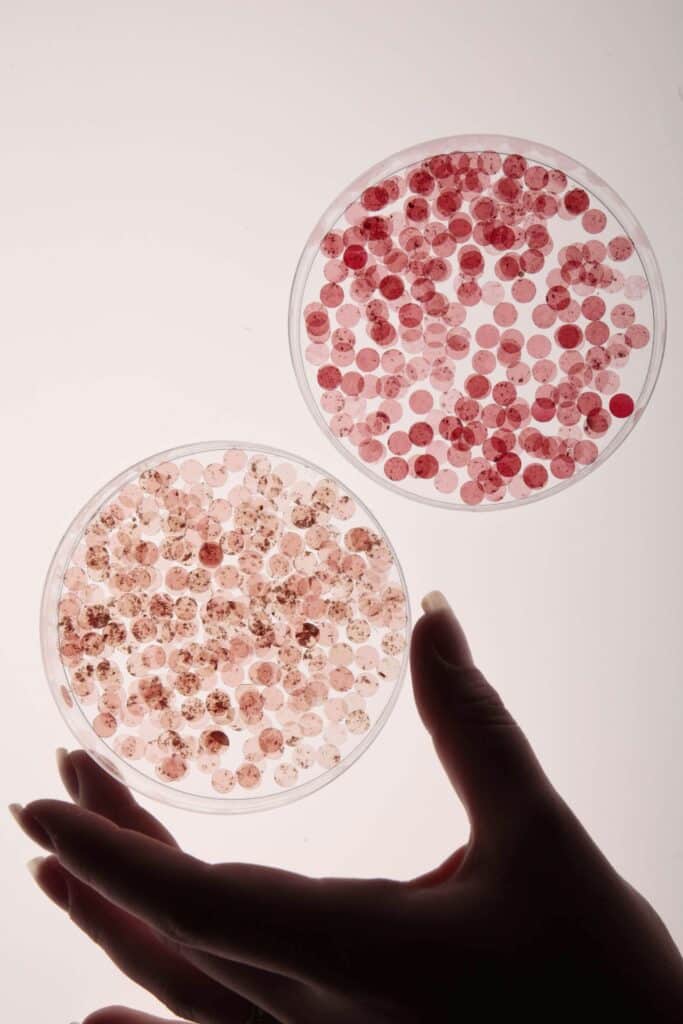
Biodegradable sequins

Sophie Boylan
Embroidery
Contact
About
Sophie Boylan is a textile artist and embroidery designer whose practice is defined by sustainability, material innovation, and storytelling through stitch. With a foundation in fashion textiles embroidery from the London College of Fashion, Sophie went on to deepen her expertise by completing a Master’s degree in Textile Design at the prestigious Royal College of Art.
In 2024, Sophie was selected for the highly regarded CHANEL and King’s Foundation Métiers d’Art Embroidery Fellowship, in partnership with Le19M. During this intensive program, she honed her craft alongside master artisans, exploring the intersection of heritage techniques and future-focused design.
Sophie’s work reimagines the possibilities of embroidery within a circular design framework. She is known for creating her own plant-based sequins using Agar and Cellulose, incorporating organic recycled flowers to provide natural color, depth, and texture. This unique approach results in pieces that are both visually striking and environmentally conscious, challenging conventional norms of embellishment and luxury.
Much of Sophie’s creative inspiration is drawn from the women in her family, as well as the rich textures and symbolism of flora and fauna. Her work often reads as a deeply personal, yet universally resonant exploration of nature, memory, and femininity-translated through meticulous craft and experimental materials.